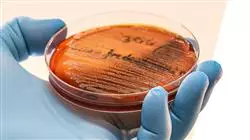

Qualificação universitária
A maior faculdade de medicina do mundo”
Porquê estudar no TECH?
Com este Curso 100% online, você dominará as estratégias mais eficazes para otimizar o diagnóstico, o tratamento e o manejo de infecções causadas por bactérias”

De acordo com dados recentes do Centro Europeu de Prevenção e Controle de Doenças, as bactérias Streptococcus, Enterococcus e Staphylococcus são responsáveis por mais de 50% das infecções nosocomiais na Europa. Os mecanismos de resistência, como a produção de beta-lactamase ou locais-alvo alterados, complicam o tratamento eficaz dessas infecções. Diante dessa realidade, os médicos precisam aprofundar sua compreensão das estratégias emergentes para gerenciar com eficiência a resistência a antibióticos nesses patógenos e, assim, melhorar o bem-estar de seus pacientes.
Dentro dessa estrutura, a TECH desenvolve um Curso revolucionário sobre Resistência a Antibióticos em Streptococcus, Enterococcus e Staphylococcus. Projetado por especialistas da área, o itinerário acadêmico explorará em profundidade o habitat natural dos patógenos Gram-positivos. Dessa forma, os graduados serão capazes de identificar os riscos de transmissão em ambientes clínicos. Além disso, a agenda abordará em detalhes as várias opções de tratamento para patologias como Streptococcus pneumoniae, Enterococcus faecium e Staphylococcus aureus. Além disso, ao longo do programa, os médicos desenvolverão habilidades avançadas para ajustar os tratamentos com antibióticos de acordo com a resposta do paciente e os resultados dos testes de sensibilidade, garantindo a máxima eficácia e minimizando os efeitos colaterais.
Vale a pena observar que o programa universitário se torna mais dinâmico graças às pílulas multimídia e à ampla variedade de recursos didáticos oferecidos pela TECH (como leituras especializadas, resumos interativos ou estudos de caso). Na mesma linha, a metodologia Relearning da TECH permitirá que os profissionais obtenham uma atualização muito mais eficaz em um período de tempo mais curto. Dessa forma, seu processo de aprendizado será totalmente natural e progressivo, de modo que não será necessário passar longas horas estudando. Além disso, a equipe de professores estará disponível o tempo todo para oferecer aos alunos uma orientação personalizada e para solucionar quaisquer dúvidas que eles possam ter sobre o programa de estudos.
Uma opção acadêmica flexível que lhe permite conciliar suas atividades diárias com uma certificação de qualidade”
O Curso de Resistência aos Antibióticos em Streptococcus, Enterococcus e Staphylococcus, Enterococcus e Staphylococcusl conta com o conteúdo científico mais completo e atualizado do mercado. Suas principais características são:
- Desenvolvimento de casos práticos apresentados por especialistas em Medicina, Parasitología e Microbiologia
- O conteúdo gráfico, esquemático e eminentemente prático oferece informações científicas e práticas sobre as disciplinas que são essenciais para a prática profissional
- Contém exercícios práticos em que o processo de auto-avaliação é realizado para melhorar o aprendizado
- Destaque especial para as metodologias inovadoras
- Aulas teóricas, perguntas a especialistas, fóruns de discussão sobre temas controversos e trabalhos de reflexão individual
- Disponibilidade de acesso a todo o conteúdo a partir de qualquer dispositivo, fixo ou portátil, com conexão à Internet
Você se concentrará nas várias opções de tratamento para combater o Streptococcus pneumoniae e melhorar o bem-estar de seus pacientes”
O corpo docente deste curso inclui profissionais da área que transferem a experiência do seu trabalho para esta capacitação, além de especialistas reconhecidos de sociedades científicas de referência e universidades de prestígio.
O conteúdo multimídia, desenvolvido com a mais recente tecnologia educacional, permitirá ao profissional uma aprendizagem contextualizada, ou seja, realizada através de um ambiente simulado, proporcionando uma capacitação imersiva e programada para praticar diante de situações reais.
A estrutura deste programa se concentra na Aprendizagem Baseada em Problemas, através da qual o profissional deverá resolver as diferentes situações de prática profissional que surgirem ao longo do curso acadêmico. Para isso, contará com a ajuda de um inovador sistema de vídeo interativo realizado por especialistas reconhecidos.
Você está procurando incorporar em sua prática as estratégias mais inovadoras para promover o uso racional de antibióticos e minimizar o desenvolvimento de resistência? Conquiste esse objetivo com o programa em apenas 150 horas"

O sistema Relearning aplicado pela TECH em seus programas reduz as longas horas de estudo tão frequentes em outros métodos de ensino"
Plano de estudos
Após a conclusão deste Curso, os médicos terão uma compreensão abrangente dos mecanismos de resistência a antibióticos em Streptococcus, Enterococcus e Staphylococcus. O programa de estudos investigará as causas das infecções bacterianas Gram-positivas, permitindo que os profissionais identifiquem os sintomas indicativos de infecção bacteriana. Além disso, o programa abordará a Mycobacterium Tuberculosis em profundidade e apresentará as diferentes opções de tratamento disponíveis. Dessa forma, os médicos adquirirão habilidades avançadas para gerenciar infecções causadas por cepas resistentes, incluindo o monitoramento de pacientes.

Estarás altamente cualificado para seleccionar los tratamientos antibióticos más efectivos basados en los perfiles de resistencia específicos de cada patógeno”
Módulo 1. Resistência a Antibióticos em Streptococcus, Enterococcus, Enterococcus e Staphylococcus
1.1. Infecções por bactérias Gram-positivas
1.1.1. Habitat natural de patógenos Gram-positivos
1.1.2. Infecções nosocomiais por bactérias Gram-positivas
1.1.3. Infecções adquiridas na comunidade por bactérias Gram-positivas
1.2. Sistemas in vitro e in vivo para o estudo da resistência em bactérias Gram-positivas
1.2.1. Biofilmes
1.2.2. Modelos celulares
1.2.3. Modelos animais
1.3. Streptococcus pneumoniae
1.3.1. Importância clínica
1.3.2. Mecanismos de resistência
1.3.3. Biofilmes
1.3.4. Opções de tratamento
1.4. Streptococcus pyogenes
1.4.1. Importância clínica
1.4.2. Mecanismos de resistência
1.4.3. Biofilmes
1.4.4. Opções de tratamento
1.5. Streptococcus agalactiae
1.5.1. Importância clínica
1.5.2. Mecanismos de resistência
1.5.3. Biofilmes
1.5.4. Opções de tratamento
1.6. Enterococcus faecalis
1.6.1. Importância clínica
1.6.2. Mecanismos de resistência
1.6.3. Biofilmes
1.6.4. Opções de tratamento
1.7. Enterococcus faecium
1.7.1. Importância clínica
1.7.2. Mecanismos de resistência
1.7.3. Biofilmes
1.7.4. Opções de tratamento
1.8. Staphylococcus aureus
1.8.1. Importância clínica
1.8.2. Mecanismos de resistência
1.8.3. Biofilmes
1.8.4. Opções de tratamento
1.9. Mycobacterium tuberculosis
1.9.1. Importância clínica
1.9.2. Mecanismos de resistência
1.9.3. Opções de tratamento
1.10. Resistência em outras bactérias Gram-positivas
1.10.1. Staphylococcus coagulasa negativo
1.10.2. Clostridioides difficile
1.10.3. Patógenos Gram-positivos emergentes
Uma aprendizagem contextualizada e realista que irá submetê-lo à realidade de uma profissão desafiadora. Matricule-se hoje mesmo!"
Curso de Resistência aos Antibióticos em Streptococcus, Enterococcus e Staphylococcus
O Curso de Resistência aos Antibióticos em *Streptococcus, Enterococcus* e *Staphylococcus* da TECH Global University é uma oportunidade única para aprofundar o estudo da resistência bacteriana, um dos desafios mais críticos da medicina contemporânea. Este programa é oferecido na modalidade de aulas online, permitindo que os alunos tenham acesso a conteúdo educacional de qualidade de qualquer lugar do mundo. Nosso instituto se compromete a fornecer uma capacitação avançada que combina conhecimentos teóricos especializados com aplicações práticas no campo da microbiologia clínica. Os alunos aprenderão sobre os mecanismos de resistência antibiótica em cepas de *Streptococcus, Enterococcus* e *Staphylococcus*, bem como as estratégias atuais para o manejo e controle de infecções resistentes. As aulas online oferecem, além disso, a flexibilidade necessária para que os profissionais de saúde possam gerenciar seu tempo de estudo de forma eficaz, sem comprometer a qualidade do ensino. Os alunos terão acesso a recursos educacionais atualizados, incluindo ferramentas interativas e simulações virtuais que enriquecem o aprendizado e facilitam a aplicação prática dos conhecimentos adquiridos.
Capacite-se na melhor Faculdade de Medicina
O programa do curso abrange desde os fundamentos da microbiologia molecular até as estratégias de tratamento com antibióticos de amplo espectro. Os alunos explorarão estudos de casos reais e desenvolverão habilidades críticas para avaliar e abordar situações clínicas complexas relacionadas à resistência bacteriana em ambientes clínicos e hospitalares. Ao final do programa, os alunos estarão preparados para enfrentar os desafios emergentes na gestão de infecções causadas por *Streptococcus, Enterococcus* e *Staphylococcus* resistentes a antibióticos. Com o respaldo da melhor Faculdade de Medicina do mundo, os graduados poderão liderar iniciativas inovadoras e contribuir para o desenvolvimento de políticas de saúde pública que promovam o uso racional de antimicrobianos. Junte-se à TECH Global University e torne-se um especialista em resistência antibiótica na microbiologia clínica. Amplie seus horizontes profissionais e faça a diferença na luta contra as infecções bacterianas mais desafiadoras do nosso tempo.